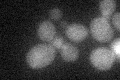
YLR172C
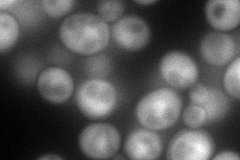
YLR172C
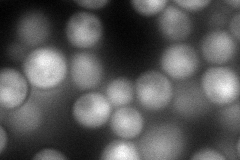
YLR172C
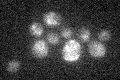
YLR172C

View description
Methyltransferase required for synthesis of diphthamide, which is a modified histidine residue of translation elongation factor 2 (Eft1p or Eft2p); not essential for viability; GFP-Dph5p fusion protein localizes to the cytoplasm
Localization:
Intensity:
Fold change:
Significance:
-
C’ GFP library in SD
below threshold16.94 -
N' NOP1pr-GFP in SD
cytosol171.7 -
N' TEF2pr-mCherry in SD
nucleus104.963 -
N' NATIVEpr-GFP in SD

cytosol20.3547 -
N' TEF2pr-VC and Cyto-VN in SD

below threshold25.9085 -
C’ GFP library in SD+DTT

cytosol16.830.99No -
C’ GFP library in SD+H2O2

cytosol17.841.05No -
C’ GFP library in Starvation Media
cytosol14.830.87No -
C’ GFP library on the background of Pup2-DaMP

below threshold -
C’ GFP library on the background of CCT mutant

below threshold16.80310.991344No
